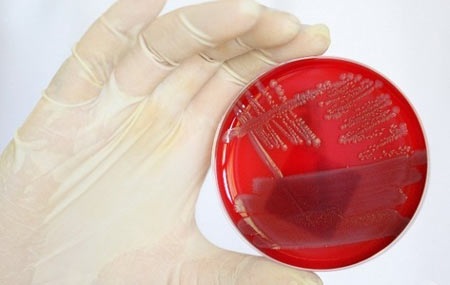
Ảnh minh họa

Vi khuẩn gây bệnh có thể sống một tuần trên máy bay
(Dân trí) - Những vi khuẩn nguy hiểm - gây nôn và nhiễm trùng nặng – có thể sống tới một tuần trên các bề mặt trong máy bay.
Ảnh minh họa
Các nhà nghiên cứu tại Trường Đại học Auburn, Mỹ đã kiểm tra khả năng sống của tụ cầu vàng kháng methicillin (MRSA) và E. coli O157:H7 trên các bề mặt thông thường trong khoang máy bay.
Những vi khuẩn gây bệnh này cư trú trên tay vịn của ghế, túi sau lưng ghế và những bề mặt quen thuộc khác.
Trong nghiên cứu, các tác giả đã đưa nhưng tác nhân gây bệnh này lên tay vịn ghế, bàn gấp bằng nhựa ở sau lưng ghế, nút nhấn kim loại ở bồn cầu, kính cửa sổ, túi vải sau lưng ghế và đồ da lấy từ một máy bay lớn.
Sau đó, họ đặt những bề mặt này trong “điều kiện điển hình của máy bay”, và thấy rằng MRSA sống lâu nhất – tổng cộng 168 giờ, hay bảy ngày – trên túi ở sau lưng ghế.
E. coli sống được 96 giờ (4 ngày) trên tay vịn ghế.
“Số liệu cho thấy những vi khuẩn này có thể tồn tại trong nhiều ngày trên các bề mặt không phụ thuộc vào loại dịch cơ thể”, các nhà nghiên cứu cho biết. Điều này có nghĩa là chúng “có nguy cơ lây truyền qua tiếp xúc da”.
Các nhà nghiên cứu cũng đang thử nghiệm những loại vi khuẩn khác, như vi khuẩn lao, cùng với các biện pháp vệ sinh và những bề mặt kháng khuẩn có thể giúp chống lại những vi khuẩn này.
Cẩm Tú
Theo Channelnewsasia










